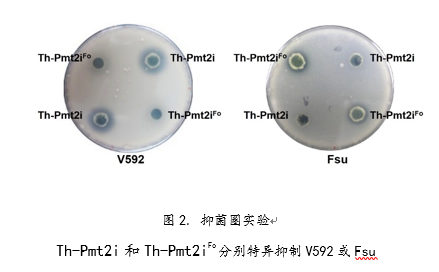

近日,中国科学院微生物研究所郭惠珊研究团队在Nature Plants杂志发表题为“Microbe-induced gene silencing boosts crop protection against soil-borne fungal pathogens”的研究论文。该研究发现了作物根际真菌的种间RNA干扰(种间RNAi),即sRNA能在真菌间传递并诱导RNAi;创建了基于种间RNAi的Microbe-induced gene silencing(MIGS)技术体系,开发了以有益微生物为“sRNA抗菌剂”天然载体的微生物制剂,可有效防治棉花和水稻的土传真菌病害。
研究团队从根际微生物中筛选得到了能进行遗传操作的益生菌(哈茨木霉,Th),以土传病原真菌(大丽轮枝菌,V592-GFP)携带的GFP为靶标,构建了能靶向目标sRNA的RNAi工程菌(Th-GFPi),创建了可视化的MIGS体系,当与Th-GFPi菌株共培养时,V592-GFP绿色荧光明显减弱(图1)。该结果证明了种间RNAi的存在,RNAi工程菌Th-GFPi能够将sRNA传递到细胞外,并进入V592-GFP真菌细胞发挥RNAi作用。

为了检验MIGS技术能否应用于作物病害防控,研究团队分别构建了靶向大丽轮枝菌(Th-Pmt2i)和尖孢镰刀菌(Th-Pmt2iFo)特异基因的工程菌。在含有大丽轮枝菌(V592)或尖孢镰刀菌(Fsu)的培养基中,Th-Pmt2i 和Th-Pmt2iFo分别特异抑制靶标真菌的生长(图2)。
在自然土壤环境中,与野生型Th相比,Th-Pmt2i菌株表现出更强的防控棉花黄萎病的作用(图3A)。同样,Th-Pmt2iFo比野生型Th表现出更强的防控水稻病害的作用,水稻株高和鲜重明显增加(图3B)。以上结果证实MIGS技术能够有效进行作物病害防控,并具有广泛性和靶标特异性。

中国科学院微生物研究所硕士研究生温汉光和赵建华副研究员为本文共同第一作者,郭惠珊研究员和赵建华副研究员为共同通讯作者。中国科学院微生物研究所张杰研究员、颜永胜研究员、高峰副研究员、张博森博士和武雪明博士参与本项研究。该研究得到了国家自然科学基金重点项目和中国科学院战略性先导科技专项(A类)的支持。
论文链接:https://www.nature.com/articles/s41477-023-01507-9
附件下载: